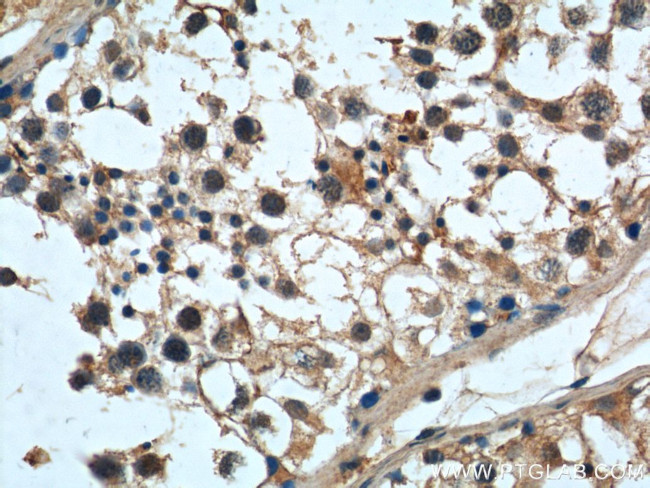
MAGEF1 Antibody in Immunohistochemistry (Paraffin) (IHC (P))
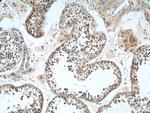
MAGEF1 Antibody in Immunohistochemistry (Paraffin) (IHC (P))

Search
Proteintech
MAGEF1 Polyclonal Antibody
{{$productOrderCtrl.translations['antibody.pdp.commerceCard.promotion.promotions']}}
{{$productOrderCtrl.translations['antibody.pdp.commerceCard.promotion.viewpromo']}}
{{$productOrderCtrl.translations['antibody.pdp.commerceCard.promotion.promocode']}}: {{promo.promoCode}} {{promo.promoTitle}} {{promo.promoDescription}}. {{$productOrderCtrl.translations['antibody.pdp.commerceCard.promotion.learnmore']}}
产品信息
24105-1-AP
种属反应
宿主/亚型
分类
类型
抗原
偶联物
形式
浓度
规格
纯化类型
保存液
内含物
保存条件
运输条件
产品详细信息
Immunogen sequence: MLQTPESRG LPVPQAEGEK DGGHDGETRA PTASQERPKE ELGAGREEGA AEPALTRKGA RALAAKSLAR RRAYRRLNRT VAELVQFLLV KDKKKSPITR SEMVKYVIGD LKILFPDIIA RAAEHLRYVF GFELKQFDRK HHTYILINKL KPLEEEEEEE DLGGDGPRLG LLMMILGLIY MRGNSAREAQ VWEMLRRLGV QPSKYHFLFG YPKRLIMEDF VQQRYLSYRR VPHTNPPAYE FSWGPRSNLE ISKMEVLGFV AKLHKKEPQH WPVQYREALA DEADRARAKA RAEASMRARA SARAGIHLW (1-308 aa encoded by BC010056 )
靶标信息
Melanoma-associated antigen (MAGE) are completely silent in normal tissues, with the exception of male germ cells, and, for some of them, placenta. These antigens ought to be strictly tumor specific, expressed in tumor cells of various histological types. Because of their specific expression on tumor cells, these antigens are of particular interest for antitumor immunotherapy. Genes of the MAGE family direct the expression of tumor antigens that are recognized on a human melanoma by autologous cytolytic T lymphocytes. Though the function of MAGE is unknown, may play a role in embryonal development and tumor transformation or aspects of tumor progression.
仅用于科研。不用于诊断过程。未经明确授权不得转售。
篇参考文献 (0)
生物信息学
蛋白别名: MAGE-F1; MAGE-F1 antigen; MAGF1; melanoma antigen family F, 1; melanoma antigen family F1; Melanoma-associated antigen F1; MGC19617
基因别名: MAGE-F1; MAGEF1
UniProt ID: (Human) Q9HAY2
Entrez Gene ID: (Human) 64110